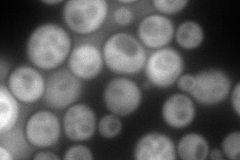
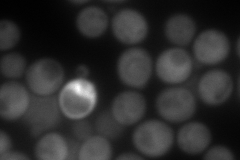
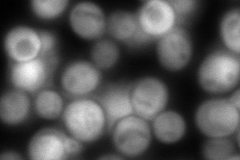
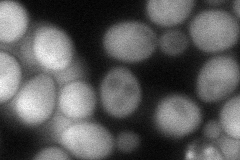
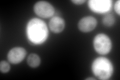

View description
Hexokinase isoenzyme 2 that catalyzes phosphorylation of glucose in the cytosol; predominant hexokinase during growth on glucose; functions in the nucleus to repress expression of HXK1 and GLK1 and to induce expression of its own gene
Localization:
Intensity:
Fold change:
Significance:
-
C’ GFP library in SD

cytosol1007.67 -
N' NOP1pr-GFP in SD
cytosol239.053 -
N' TEF2pr-mCherry in SD
cytosol271.965 -
N' NATIVEpr-GFP in SD
cytosol403.758 -
N' TEF2pr-VC and Cyto-VN in SD
cytosol90.3603 -
C’ GFP library in SD+DTT
cytosol1569.631.55Yes -
C’ GFP library in SD+H2O2

cytosol952.370.94No -
C’ GFP library in Starvation Media

nucleusN/AN/ANo -
C’ GFP library on the background of Pup2-DaMP

cytosol -
C’ GFP library on the background of CCT mutant

cytosol917.2410.910251No
